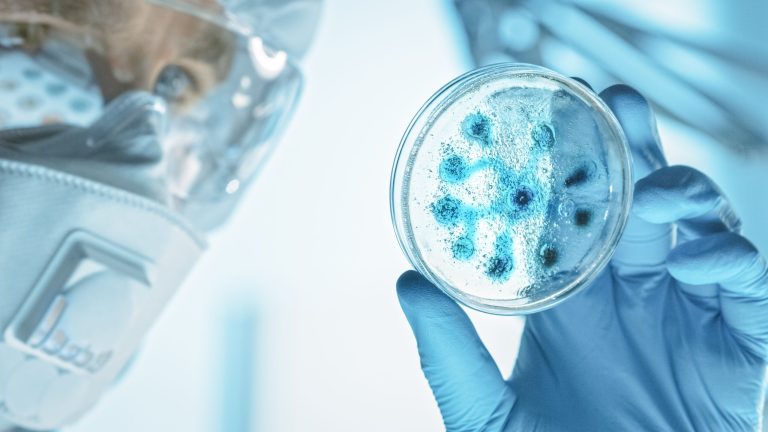
AdobeStock 330354770

Un domaine d’expertise regroupe un champ de savoirs, de compétences et d’aptitudes dans lequel nos intervenants et intervenantes possèdent une maîtrise approfondie, justifiée par une expérience significative à la fois théorique et sur le terrain.
Consolider vos domaines d’expertise, c’est affermir et élargir votre champs d’actions permettant de vous démarquer de la concurrence et de faire évoluer votre carrière. Retrouvez dans nos formations les connaissances à acquérir pour répondre aux défis de demain.